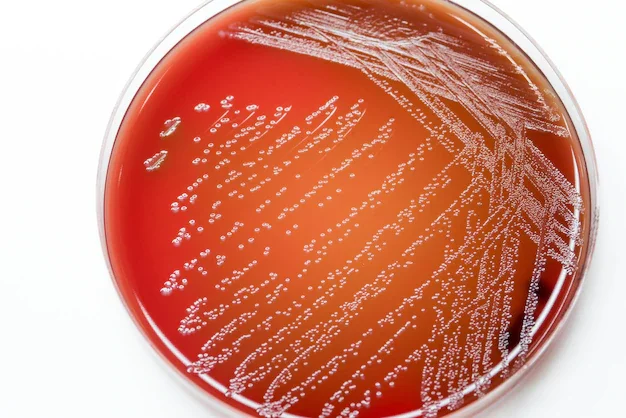
Robert Koch
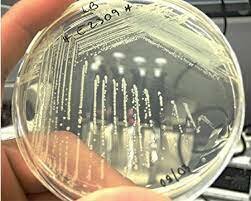
Marinus Beijerinck

-
 Micrographia.
Micrographia.
Robert Hooke (1635-1703),un matemático y naturalista inglés, fue tambien un excelente microscopista.
En su famosos libro Micrographia , que fue el primero dedicado a observaciones microscópicas, Hooke describió, entre otras cosas, los cuerpos fructificantes de los mohos, lo que representa la primera descripción conocida de los microorganismos. -
 Descubrimiento de las bacterias.
Descubrimiento de las bacterias.
La primera persona que vió bacterias fue el comerciante holandés Antonie Van Leeuwenhoek (1632-1723), que también era un aficionado a construir microscopios. En 1684, van Leeuwenhoek, que ya conocía el trabajo de Hooke, empleó microscopios muy simples de construcción propia para examinar el contenido microbiano de varias sustancias naturales. -
 Vacunación contra la viruela vacuna.
Vacunación contra la viruela vacuna.
Edward Jenner tomó material de una lesión pustular de viruela de vacas causada por el cowpox virus, obtenido de la mano de la ordeñadora Sarah Nelmes y lo inoculó en el brazo de James Phipps, niño de 8 años, hijo del jardinero de la familia Jenner. Dos meses después inoculó material de una lesión proveniente de un enfermo con viruela y demostró que James no contrajo la enfermedad planteando que había quedado “inmune”. -
 Microbiología de la fermentación lácctica.
Microbiología de la fermentación lácctica.
Pasteur demostró que los agentes de la fermentación láctica eran microorganismos, trabajando sobre un problema que había surgido entre los destiladores de Lille cuando en sus cubas la fermentación alcohólica se vio sustituida por una indeseable fermentación láctica. -
 Función de las levaduras en la fermentación alcohólica.
Función de las levaduras en la fermentación alcohólica.
Industriales locales tenían problemas para la obtención de alcohol por fermentación del azúcar de remolacha e invitaron a Pasteur a realizar un estudio a fondo.Uno de los productos de la fermentación es el alcohol amílico,Pasteur lo detectó en el líquido de fermentación encontrando que era ópticamente activo.Observaciones microscópicas y experimentos,demostraron que la fermentación alcohólica estaba catalizada por las levaduras. -
 Fin de la controversia sobre la generación espontánea.
Fin de la controversia sobre la generación espontánea.
Pasteur fue un ferviente adversario de la generación espontánea. Tras sus descubrimientos sobre la fermentación, demostró que en el aire había estructuras que se parecían mucho a los microorganismos encontrados en el material putrefacto y concluyó que aquellos presentes en dicho material derivaban de los que había en el aire y en la superficie de los recipientes que los contenían. -
 Principios antisépticos en cirugía.
Principios antisépticos en cirugía.
El método preconizado por Lister contemplaba tres etapas: destrucción de los gérmenes y organismos vivos antes de la operación, durante el acto quirúrgico, y defensa contra aquellos después de la intervención operatoria. Todo esto se obtenía fundamentalmente utilizando la llamada "solución fuerte" de ácido fénico al 5% para sumergir en ella los instrumentos usados en la operación. -
 Descubrimiento de las endosporas.
Descubrimiento de las endosporas.
Cohn se interesó por la resistencia de las bacterias al calor, descubriendo así las endosporas.Describió el ciclo de vida completo de Bacillus (bacteria formadora de endosporas) y observó que las células vegetativas de Bacillus morían por ebullición, pero no las endosporas,esto ayudó a explicar por qué la ebullición era generalmente un método apropiado para evitar que las infusiones líquidas permitieran el crecimiento microbiano, aunque no siempre era así. -
Métodos de estudio de bacterias en cultivo axénico.
Métodos de estudio de bacterias en cultivo axénico.
Koch observó que cuando se exponía al aire la superficie de un nutriente sólido se desarrollaban colonias bacterianas con formas y colores característicos. Dedujo que cada colonia se originaba a partir de una sola célula bacteriana que había caído sobre la superficie y con nutrientes adecuados se había multiplicado.Cada colonia era por lo tanto una población de células idénticas, es decir, cada colonia representaba un cultivo axénico o puro. -
 Fagocitosis.
Fagocitosis.
Cuando Metchnikoff se dispuso a examinar una larva de estrella de mar,observó un racimo de células que recubrían la espina e intentaban absorberla, por lo que vio en seguida el significado: las células se aprestaban a defender a la larva mediante la digestión del invasor, en un proceso de fagocitosis y entendió que constituía un mecanismo fundamental mediante el cual los organismos de todo el reino animal se defendían contra las infecciones. -
 Etiología de la tuberculosis.
Etiología de la tuberculosis.
Koch diseñó un procedimiento para teñir M. tuberculosis en muestras de tejidos usando azul de metileno alcalino y un segundo colorante (marrón Bismark) que teñía sólo los tejidos; las células bacilares de M. tuberculosis eran teñidas de azul en tejidos tuberculosos, mientras éstos últimos quedaban teñidos de marrón claro. Finalmente Koch tuvo éxito al obtener colonias de este organismo sobre suero de sangre coagulada y posteriormente usó agar. -
 Etiología del cólera;Postulados de Koch.
Etiología del cólera;Postulados de Koch.
Koch empleó ratones como animales experimentales.
Usando los controles apropiados, demostró que cuando
una pequeña cantidad de sangre de un ratón enfermo se
inyectaba en uno sano se provocaba rápidamente en ésta la aparición de carbunco. Tomando sangre de este segundo animal e inyectándola en otro, obtenía de nuevo los síntomas de la enfermedad. -
 Método de la tinción de Gram.
Método de la tinción de Gram.
Mientras Gram se encontraba en Berlín, intentó establecer la diferencia entre dos bacterias causantes de la neumonía: Klebsiella Pneumoniae y el ‘Neumococo’. Para ello, realizó un proceso de coloración de las bacterias que consistió en añadir violeta de genciana, fijación con yodo en una solución de yoduro de potasio y, finalmente, realizar un lavado con etanol. -
 Vacuna contra la rabia.
Vacuna contra la rabia.
El Dr. Louis Pasteur inyecta una serie de vacunas nuevas contra la rabia a un niño al que le mordió un perro con rabia. El niño sobrevive. Esta es la primera vacuna que protege a las persona contra la rabia. Antes de la vacuna antirrábica, casi todas las personas que se infectaban, morían de rabia. -
 Concepto de quimiolitotrofía.
Concepto de quimiolitotrofía.
Propuso el concepto de quimiolitotrofía, es decir, la oxidación de
compuestos inorgánicos acoplada a la obtención de energía utilizable. Además, estudiando el proceso de nitrificación (oxidación del amoníaco a nitrato) llegó a la conclusión de que las bacterias nitrificantes responsables de este hecho obtenían su carbono del CO2 del aire, es decir que, como las bacterias fotótrofas, eran autótrofas. -
 Concepto de virus.
Concepto de virus.
Si bien Ivanovsky no pudo identificar qué causaba la enfermedad del mosaico del tabaco, sí aportó un dato clave; logró determinar que se trataba de un agente filtrable.Fue Beijerinck, quien logró avanzar aún más con el estudio de este nuevo agente infeccioso.Además de describir algunas de sus propiedades, a Beijerinck se le atribuye haber bautizado a este patógeno como un "virus", palabra derivada de un término latín que significa "líquido viscoso" o "veneno". -
 Antitoxina diftérica.
Antitoxina diftérica.
Descubrieron que la inmunidad a la difteria podía producirse mediante inyección en animales de toxina diftérica neutralizada por la antitoxina. -
 Grupos sanguíneos humanos.
Grupos sanguíneos humanos.
El Nobel Karl Landsteiner estableció la clasificación de los grupos sanguíneos y descubrió que se transmitían según el modelo de herencia genética descrita por las leyes de Mendel.
El sistema ABO fue el primero que descubrió Landsteiner. En este caso, las sustancias que determinan el grupo sanguíneo son los azúcares adheridos a la superficie de los glóbulos rojos, y según su composición encontramos cuatro grupos: A, B, AB y O. -
Método de cultivo de enriquecimiento .
Método de cultivo de enriquecimiento .
Por esta técnica los microorganismos se aislan de muestras naturales de un modo muy selectivo mediante la manipulación de las condiciones nutricionales y de incubación. Beijerinck aisló los primeros cultivos puros de muchos microorganismos del suelo y del agua, bacterias sulfatoreductoras y oxidantes de azufre, fijadoras de nitrógeno de los nódulos radiculares, diversas especies de Lactobacillus, algas verdes, bacterias anaerobias, etc. -
 Agentes quimioterapeúticos.
Agentes quimioterapeúticos.
Con el medicamento salvarsán, Paul Ehrlich marcó un hito. La arsfenamina (arsénico orgánico) fue el primer remedio eficaz contra la sífilis, y el comienzo de la quimioterapia. “Logró curar incluso a personas que ya estaban deformadas por la enfermedad”. -
 Primer virus oncogénico.
Primer virus oncogénico.
Rous consiguió aislar tal virus de un tumor canceroso de un pollo; infectó con él a otros pollos, que desarrollaron el mismo tumor. Ello supuso la primera prueba de que los virus son capaces de producir tumores cancerosos. Por sus descubrimientos sobre el tratamiento del cáncer de próstata con hormonas recibió el premio Nobel de Fisiología y Medicina de 1966. -
 Virus bacterianos (bacteriófagos).
Virus bacterianos (bacteriófagos).
El bacteriólogo Frederick Twort publicó el primer artículo sobre los virus que infectan bacterias, se replican en su interior y las matan. Desde entonces, el estudio de los bacteriófagos, conocidos popularmente como «fagos», ha transformado la biología. -
 Transformación en neumococos.
Transformación en neumococos.
Griffith observó que los ratones inyectados con una cantidad del cultivo R, junto con un inóculo de la cepa L, previamente inactivada por calor, morían frecuentemente por la infección. En la sangre obtenida por punción cardíaca de los animales moribundos se recuperaba sólo el neumococo tipo L en cultivo puro y concluyó que las bacterias muertas L, habían conservado cierta capacidad para transmitir su aptitud de producir cápsulas-viscosas a la cepa R. -
 Descubrimiento de la penicilina.
Descubrimiento de la penicilina.
Cuenta la historia que el médico británico Alexander Fleming descubrió la penicilina por casualidad cuando trabajaba con cultivos de bacteria y, al irse de vacaciones, sus muestras se cubrieron de un hongo de la cepa Penicillium notatum, que destruyeron las bacterias. -
 H2S (sulfuro) como donador de electrones en la fotosíntesis anoxigénica.
H2S (sulfuro) como donador de electrones en la fotosíntesis anoxigénica.
En la fotosíntesis anoxigénica, los organismos fotoautótrofos anoxigénicos convierten la energía de la luz en energía química necesaria para el crecimiento; sin embargo, y al contrario que las plantas, algas y cianobacterias, en este proceso de transformación de la energía no se produce oxígeno. -
 Sulfamidas.
Sulfamidas.
Domagk obtuvo el premio Nobel por el descubrimiento de la sulfonamida Prontosil, primera droga efectiva contra las infecciones bacterianas. -
 Herencia de caracteres genéticos en bacterias.
Herencia de caracteres genéticos en bacterias.
En bacterias en crecimiento, por ejemplo, las paredes celulares rígidas se sintetizan y simultáneamente se cortan con enzimas. Si un experimentador elimina por completo la pared celular de una bacteria, el equilibrio entre la síntesis de la pared y la destrucción se desplaza, y la bacteria continúa creciendo y multiplicándose indefinidamente sin paredes. La desnudez bacteriana es claramente una característica adquirida que se hereda. -
 El DNA es el material genético.
El DNA es el material genético.
El ADN, o ácido desoxirribonucleico, es el material que contiene la información hereditaria en los humanos y casi todos los demás organismos. Casi todas las células del cuerpo de una persona tienen el mismo ADN. -
 Descubrimiento de la estreptomicina.
Descubrimiento de la estreptomicina.
La estreptomicina, un antibiótico que fue muy útil en el siglo pasado para tratar la tuberculosis, fue descubierta un 19 de octubre por el estudiante de postgrado Albert Schatz, cuando cursaba su doctorado en la Universidad de Rutgers (EE. UU.) en Agricultura, en el laboratorio del famoso Dr.Waksman a quién hasta la década de los años noventa, le fue atribuido este descubrimiento. -
 Conjugación bacteriana.
Conjugación bacteriana.
Empleando la selección prototrófica, es decir, sembrando la mezcla en medios de cultivo donde las bacterias tienen que sintetizar todos los compuestos para poder crecer, pudieron encontrar bacterias que se habían “liberado” de la necesidad de estos compuestos. Quedada claro que las bacterias originales habían mezclado sus genes y originado nuevas bacterias sin esos requerimientos, en un fenómeno que fue bautizado como conjugación. -
 Descubrimiento de los transposones.
Descubrimiento de los transposones.
El descubrimiento de los transposones se debe a Barbara McClintock en maíz durante los años 40, que propuso que los cambios de color observados en los granos del maíz durante la mitosis eran producidos por "elementos controladores" que cambian de posición dentro del genoma. -
 Transducción bacteriana.
Transducción bacteriana.
Transducción generalizada. La transducción es un proceso mediante el cual el ADN externo es transferido desde una bacteria a otra mediante la acción de un virus. Este mecanismo tambien puede desarrollar en las células. -
 Estructura del DNA.
Estructura del DNA.
Las bases de ADN se emparejan entre sí, adenina (A) con timina (T) y citosina (C) con guanina (G); para formar unidades llamadas pares de bases. Cada base también está unida a una molécula de azúcar y una molécula de fosfato. Juntos (una base, un azúcar y un fosfato) se llaman nucleótidos. Los nucleótidos están dispuestos en dos hebras largas que forman una espiral llamada doble hélice. -
 Teoría de la selección clonal.
Teoría de la selección clonal.
Según la teoría de la selección clonal, los animales contienen numerosas células denominadas linfocitos, y cada linfocito responde a un antígeno particular en virtud de moléculas receptoras específicas de superficie. -
 Estructura de las inmunoglobulinas.
Estructura de las inmunoglobulinas.
Las primeras investigaciones sobre la estructura de los anticuerpos fueron realizados mediante digestiones con pepsina y papaína , seguidas de electroforesis. -
 Regulación génica por proteínas represoras.
Regulación génica por proteínas represoras.
La regulación génica es el proceso que se usa para controlar el momento, la ubicación y el nivel de expresión de los genes. El proceso puede ser complicado y se lleva a cabo por diversos mecanismos, que incluyen proteínas reguladoras y modificación química del ADN. -
 Concepto de operón.
Concepto de operón.
El operón nació en la búsqueda emprendida por Jacob y Monod en el mecanismo genético de la inducción de la β-galactosidasa. Su hipótesis de trabajo era que existía un inductor endógeno, no identificado, que explicaba el nivel constante de esta enzima en el interior de las células. -
 mRNA y ribosomas en la síntesis proteica .
mRNA y ribosomas en la síntesis proteica .
El ribosoma lee la secuencia del ARN mensajero (ARNm) y traduce ese código genético en una serie especificada de aminoácidos, que crece y forma cadenas largas que se pliegan y forman proteínas. -
 Descubrimiento del código genético.
Descubrimiento del código genético.
El código genético es el término que usamos para nombrar la forma en que las cuatro bases del ADN : A, C, G y T se encadenan de forma que la maquinaria celular, el ribosoma, pueda leerlos y convertirlos en una proteína. -
 Bacterias capaces de crecer en agua en ebullición.
Bacterias capaces de crecer en agua en ebullición.
Los organismso extremos (hiper) termófilos viven a temperaturas muy altas. Además de las características unificadoras de las arqueobacterias, (pared celular sin mureína, lípidos de membranas con enlaces éter, etc.), estos procariotas exhiben atributos bioquímicos que le permiten adaptarse a estos ambientes extremos. -
 Descubrimiento de retrovirus y transcriptasa inversa.
Descubrimiento de retrovirus y transcriptasa inversa.
En el campo de la biología, el proceso celular por el que una enzima hace una copia de ADN del ARN. La enzima que hace la copia de ADN se llama retrotranscriptasa y se encuentra en los retrovirus, tales como el virus de la inmunodeficiencia humana (VIH). -
 Técnicas de DNA recombinante.
Técnicas de DNA recombinante.
El ADN recombinante (rADN) es una tecnología que utiliza enzimas para cortar y unir secuencias de ADN de interés. Las secuencias de ADN recombinado se pueden colocar en unos vehículos llamados vectores que transportan el ADN hacia el lugar adecuado de la célula huésped donde puede ser copiado o expresado. -
 Anticuerpos monoclonales.
Anticuerpos monoclonales.
Su verdadera importancia es que el trabajo abrió una nueva etapa en la Medicina, ya que al fusionar los linfocitos B, que tienen una vida media limitada en la producción de anticuerpos, con las células tumorales de vida limitada, se logró un híbrido de ambas de acción permanente, lo que significó un gran avance en la inmunología moderna, sobre todo para el diagnóstico y tratamiento de gran número de enfermedades. -
 Reordenación en genes de inmunoglobulinas.
Reordenación en genes de inmunoglobulinas.
Los genes de las inmunoglobulinas consisten en numerosos segmentos codificantes discontinuos. A medida que la célula B se desarrolla y madura, estos segmentos de ADN se reordenan de una manera controlada, de tal forma que cada célula B madura tiene un perfil de reordenamiento único -
 Métodos de secuenciación del DNA.
Métodos de secuenciación del DNA.
La secuenciación del ADN es un conjunto de métodos y técnicas bioquímicas cuya finalidad es la determinación del orden de los nucleótidos en un oligonucleótido de ADN. -
 Descubrimiento de Archaea.
Descubrimiento de Archaea.
Se observan por primera vez arqueas de Asgard, microbios cuyos ancestros dieron el primer paso para la aparición de animales y plantas hace 2.000 millones de años. -
 Caracterización de los priones.
Caracterización de los priones.
Los priones son proteínas infecciosas que se comportan como genes, esto es, proteínas que no solo contienen información genetica en su estructura terciaria, es decir en su conformación, sino que también son capaces de transmitirla y replicarla en forma análoga a los genes pero por medio de mecanismos muy distintos. -
 Descubrimiento del VIH como causa del SIDA.
Descubrimiento del VIH como causa del SIDA.
En esa época experimentaban con la adición de anticuerpos contra interferón a los cultivos de virus en líneas celulares para facilitar su crecimiento, ya que el interferón ejerce un efecto inhibidor en la replicación viral.Según el propio Montagnier, tuvo conocimiento acerca de la hipótesis que involucraba a un retrovirus como la causa de la nueva enfermedad y a finales de este mismo año iniciaron los experimentos relacionados con esta teoría. -
 Reacción en cadena de la polimerasa (PCR).
Reacción en cadena de la polimerasa (PCR).
PCR, o la reacción en cadena de la polimerasa, es una reacción química que los biólogos moleculares utilizan para amplificar (crear copias) fragmentos de ADN. Esta reacción permite que unos pocos fragmentos de ADN se repliquen en millones o miles de millones de copias. -
 Tinciones filogenéticas.
Tinciones filogenéticas.
Las tinciones son el primer paso, y a veces el único, para la identificación bacteriana. La mayoría de los colorantes utilizados en bacteriología se derivan de la anilina, que tienen como estructura básica anillos de benceno unidos que se comportan como cromóforos, y fuerte afinidad por el hidrógeno, unos son ácidos y otros básicos. -
 El muestreo de los genes del RNA ribosomal revela la enorme
El muestreo de los genes del RNA ribosomal revela la enorme
diversidad bacteriana en la naturaleza. -
 Descubrimiento de Archaea marinas
Descubrimiento de Archaea marinas
La microbiología marina goza en la actualidad de una gran popularidad porque encierra muchas posibilidades para el estudio de la biodiversidad y de las actividades de los microorganismos marinos, y sobre todo por el reconocimiento de que tales microorganismos marinos probablemente controlan muchos parámetros globales críticos, como el clima y la composición de la atmósfera. -
 Primera secuenciación de un genoma
Primera secuenciación de un genoma
La secuenciación del ADN significa determinar el orden de las "bases", que forman la molécula de ADN. La secuencia les informa a los científicos la clase de información genética que se transporta en un segmento específico de ADN. La información de las secuencias es utilizada para determinar qué tramos de ADN contienen genes y qué tramos transportan instrucciones regulatorias, que activan o desactivan genes. -
 Primer proyecto de metagenómica a gran escala
Primer proyecto de metagenómica a gran escala
El dinámico campo de la genómica ha dado origen, a su vez, a otras disciplinas como la proteómica y la metabolómica, que estudian respectivamente los modelos de expresión proteica y metabólica de las células.
Plan projects on a visual timeline
Map milestones, phases, deadlines, and key events in one place so the sequence is easier to see and share. Timetoast is a timeline maker for work, school, research, and stories.
